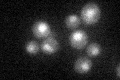
YPL193W
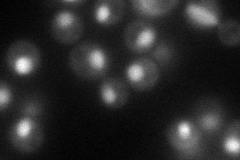
YPL193W
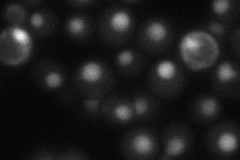
YPL193W
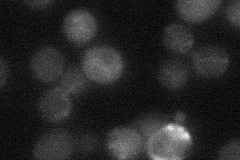
YPL193W
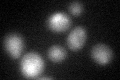
YPL193W

View description
Protein involved in the assembly of 60S ribosomal subunits; functionally interacts with Dbp6p; functions in a late nucleoplasmic step of the assembly
Localization:
Intensity:
Fold change:
Significance:
-
C’ GFP library in SD
nucleus24.04 -
N' NOP1pr-GFP in SD
nucleus73.5806 -
N' TEF2pr-mCherry in SD
nucleus31.5308 -
N' NATIVEpr-GFP in SD
below threshold20.2177 -
N' TEF2pr-VC and Cyto-VN in SD

#N/A0 -
C’ GFP library in SD+DTT
nucleus23.150.96No -
C’ GFP library in SD+H2O2

nucleus21.970.91No -
C’ GFP library in Starvation Media

nucleus33.111.37Yes -
C’ GFP library on the background of Pup2-DaMP

nucleus -
C’ GFP library on the background of CCT mutant

nucleus23.15960.96328No
